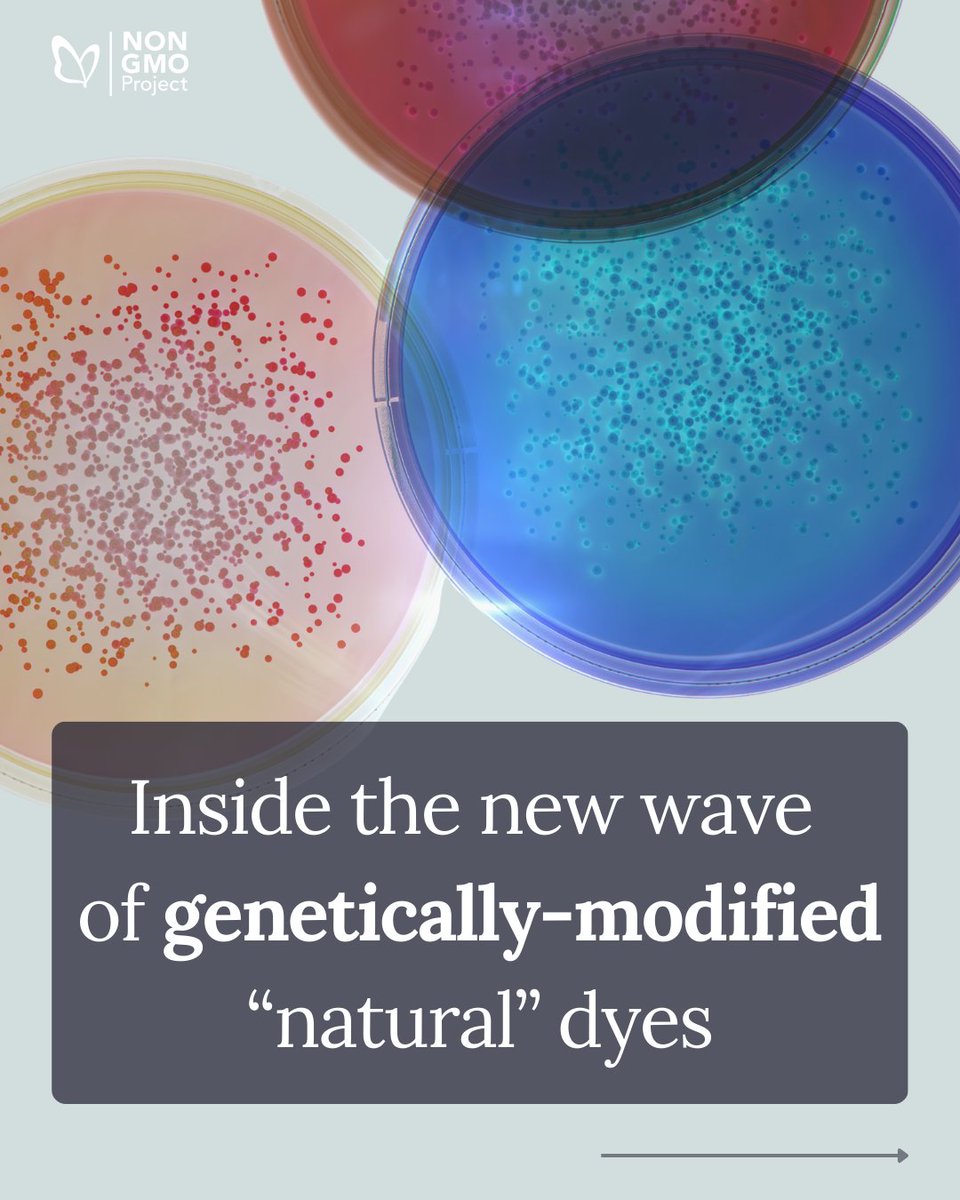
Non-GMO Project tweet media

As the market shifts away from synthetic #fooddye, #biotech startups are creating alternatives with #syntheticbiology, branding them as “natural.”
💭 Do we need more dyes in our food? And do you consider GMO-derived food dyes to be “natural”?

English






































